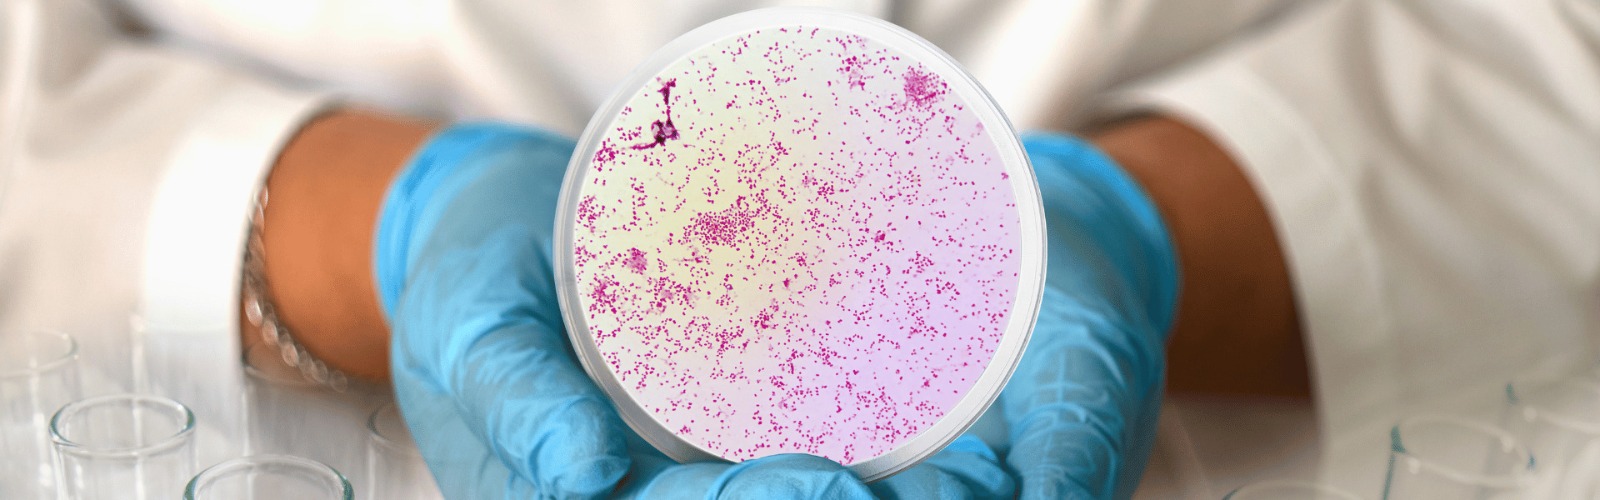

أخبار العالم
طرح أول لقاح فى العالم ضد مرض السيلان
وهج الخليج ـ وكالات
أعلن مسؤولون اليوم الأربعاء أنه سيتم طرح لقاح ضد مرض السيلان في انجلترا ضمن برنامج هو الأول من نوعه فى العالم . وذكرت وكالة الأنباء البريطانية (بي ايه ميديا) أن هذه الخطوة، التي وصفت بأنها ” لحظة تاريخية للصحة الجنسية” تهدف للتغلب على المستويات المرتفعة من الأمراض المنقولة جنسيا. ويأتي ذلك بعدما تجاوزت حالات الاصابة بمرض السيلان في انجلترا 85 ألف حالة خلال 2023، فيما يعد أعلى عدد يتم تسجيله منذ بدء عملية التسجيل عام 1918، في ظل تحذيرات من أن بعض السلالات تقاوم المضادات الحيوية. وسوف يتم تحديد المرضى الذين يحق لهم الحصول على اللقاح والتواصل معهم في الأسابيع المقبلة، على أن يبدأ توزيع اللقاح من خلال قطاع خدمات الصحة الجنسية بتكليف من السلطات المحلية في الأول من أغسطس المقبل.




